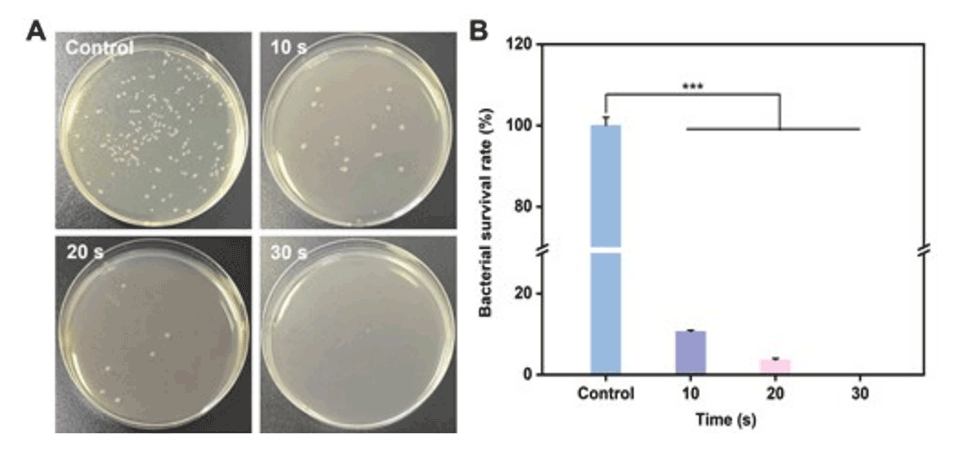

导读:
卵母细胞冷冻保存在辅助生殖领域至关重要,但由于卵母细胞体积大、环境耐受性差,细胞冷冻技术有待进一步改进。近期,中国科学院合肥物质科学研究院王振洋、李年等人通过结合激光诱导石墨烯(LIG)技术和光纤刻蚀技术,巧妙地设计出了一种基于三维石墨烯的Y型微流控芯片,用于高性能的卵子冷冻保存。相关研究以“Multifunctional Laser-induced Graphene-based Microfluidic Chip for High-performance Oocyte Cryopreservation with Low Concentration of Cryoprotectants”为题目,发表在期刊《Advanced Healthcare Materials》上。
本文要点:
1、本文介绍了一种基于激光诱导石墨烯(LIG)和光纤蚀刻技术的Y型微流控芯片,用于高性能的卵子冷冻保存。
2、该芯片通过调整表面疏水性有效抑制冰晶尺寸并延迟冰晶形成时间,同时利用LIG的优异光热效应,在10秒低功率808nm激光照射下,芯片的表面温度可从25℃骤升至71.8℃。
3、使用该LIG/PDMS微流控芯片,即使在减半浓度的冷冻保护剂(7.5% EG和7.5% DMSO)下,小鼠卵子的存活率仍高达92.4%,显著高于对照组的85.8%。
4、因此,本工作为构建用于高性能卵母细胞冷冻保存的多功能微流控芯片提供了一种新颖的设计策略。
全文总结/概括:

卵母细胞冷冻保存面临的挑战主要包括:
1、卵子的敏感性:卵子相对于其他细胞具有较小的表面积与体积比,含水量高,膜渗透性差,对温度和渗透压变化的耐受性较低,导致冷冻后存活率不高。
2、冷冻保护剂的使用:目前常用的玻璃化方法是通过添加高浓度的冷冻保护剂(如乙二醇和二甲基亚砜)来实现卵子的快速冷却和长期保存,但高浓度的冷冻保护剂在装载过程中会改变细胞内外的渗透压,引起细胞体积的剧烈变化和渗透损伤。
3、冷冻保护剂的毒性:高浓度的冷冻保护剂对细胞有严重的负面影响,甚至可能导致细胞死亡。
4、复苏过程中的冰晶重结晶:在卵子复苏过程中,冰晶重结晶可能导致严重的机械损伤,如细胞膜破裂和细胞死亡。
5、多步骤的洗涤过程:冷冻后的卵子需要经过多步骤的洗涤来去除有毒的高浓度冷冻保护剂,这增加了渗透冲击的风险和卵子损失的可能性。
6、技术复杂性:现有的微流控技术主要用于冷冻保护剂的装载和卸载,但并未能减少冷冻保护剂的浓度,且制备方法复杂,限制了其在卵子冷冻保存中的应用。
本研究开发的多功能激光诱导石墨烯(LIG)微流控芯片是如何解决上述挑战的?
1、冰晶控制:利用LIG的多孔结构和高疏水性,芯片能有效调节冰晶成核和抑制冰晶重结晶,减少冰晶对卵子的机械损伤。
2、光热效应:LIG/PDMS微流控芯片具有出色的光热效应,能在低功率激光照射下迅速提升表面温度,加速卵子的解冻过程,降低冰晶重结晶导致的损伤。
3、减少冷冻保护剂用量:通过优化微流控芯片的设计,即使在减半浓度的冷冻保护剂(7.5% EG和7.5% DMSO)下,也能保持卵子的高存活率,减少了对高浓度冷冻保护剂的依赖。
4、简化制备过程:利用激光诱导技术和光纤蚀刻技术,简化了微流控芯片的制备过程,使其更易于大规模生产和应用。
5、提高生物相容性:通过实验验证了LIG/PDMS微流控芯片具有高度的生物相容性,适合用于细胞冷冻保存。
6、抗细菌性能:LIG/PDMS芯片在低功率激光照射下展现出良好的抗细菌性能,有助于保持冷冻保存过程中的无菌环境。
7、保持卵子的发育潜能:通过体外受精(IVF)和胚胎发育实验,证实了使用该微流控芯片冷冻保存的卵子能够保持其生育和发育能力。
通过这些创新的设计和功能,本研究开发的LIG/PDMS微流控芯片为卵子冷冻保存提供了一种高效、低损伤、操作简便的解决方案。

图1.(A)LIG/PDMS微流控芯片的制备过程示意图。(B)LIG的SEM图像和LIG的横截面(插图)。(C)LIG/PDMS-0的SEM图像和LIG/PDMS-0的横截面(插图)。(D)LIG/PDMS微流控芯片的Y型通道截面的SEM图像。(E)不同光纤激光扫描间距下Y型通道表面的水接触角。(F)LIG/PDMS微流控芯片的Y型通道截面的截面SEM图像。(G)LIG/PDMS微流控芯片另一部分的横截面SEM图像。(H)用荧光墨水对制备的LIG/PDMS微流控芯片进行密封试验。

图2.LIG/PDMS微流控芯片的表征。

图3.(A)水和LIG溶液(1mg/mL)的DSC热谱图。(B)从DSC图像获得的水和LIG的冰晶形成和融化温度。(C)水LIG溶液(1mg/mL)中冰晶的显微镜图像和相应的尺寸分布(插图)。(D)MLGS的定量分析。Y轴表示水和LIG溶液的MLGS(使用Nano Measure软件计算图像中最大的20个冰晶尺寸,每次平行测定n=3-5个图像)。(E)在不同表面上的抑冰性能测试(纸张、LIG/PDMS-0.1和LIG-PDMS-0.4)。误差条的值由数据的标准偏差(SD)决定。所有数据均以平均值±标准差表示。***p≤0.001。

图4.LIG/PDMS微流控芯片的光热性能测试。

图5.(A)用LIG/PDMS微流控芯片冷冻和复苏Hela细胞的示意图。(B)冷冻保存和复苏后培养24小时的Hela细胞的活/死细胞(绿色/红色)荧光染色图像,使用不同的细胞冷冻保存溶液,通过808nm激光(0.4W/cm2)加热。(C)冷冻保存和复苏后培养24小时的Hela细胞的细胞活力,使用不同的细胞冷冻保存溶液,通过808nm激光(0.4W/cm2)加热(n=3)。误差条表示SD。(**p≤0.01,***p≤0.001)。

图6.(A)LIG/PDMS微流控芯片用于卵母细胞玻璃化冷冻保存和复苏的实验工作流程示意图。(B)使用不同玻璃化冷冻保护剂(808nm激光,0.4W/cm2)的卵母细胞的冷冻复苏存活率(n=3)。(C)卵母细胞明场和荧光染色的图像(新鲜、对照和CPA-2)。(D)新鲜组、对照组和CPA-2组MMP的荧光染色图像。(E)JC-1红/绿荧光速率的定量分析。每次平行测定n=10-20。n:每个实验中使用的小鼠卵母细胞的数量。误差条表示SD。(ns:p>0.05,*p≤0.05,**p≤0.01,***p≤0.001)。
图7.LIG/PDMS微流控芯片对大肠杆菌的抗菌性能。
原文链接:https://doi.org/10.1002/adhm.202400981






